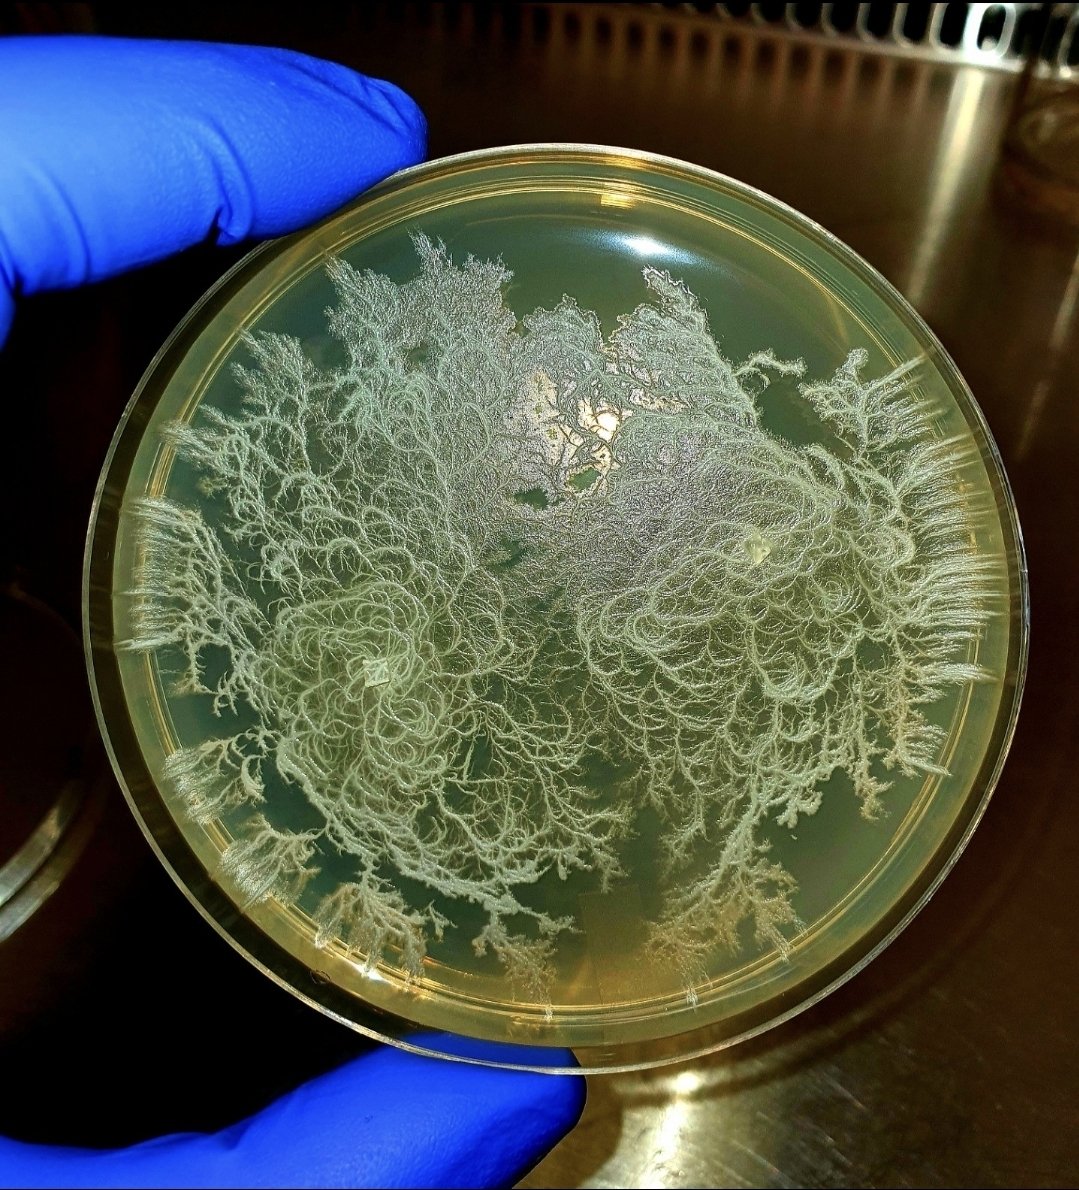
Aamer Kurdi tweet media

عزيزة الفؤاد
623 posts

عزيزة الفؤاد
@turtlescanfly0
بهيّة، حرة، محبوبة المحبين في رواية! 92
Katılım Mart 2026
53 Takip Edilen55 Takipçiler

مدري كيف اشرح لكم بس فيه رجال يغارون من اصدقائهم المتزوجين السعيدين بتالي بعضهم يزهدون المتزوج بزوجته وبعضهم يدعونه يتزوج الثانية ..
مو كل من يمزح بذا الطاري فعلًا غيران بس يكاد اقول الأكثرية
A@onthetrackAa
على طاري الزواج مره كنا بجلسه وفي واحد من العيال ينصح متزوج انه ياخذ الثانيه وجالس يصر ويزن عليه لين انفجر المتزوج قاله انت عمرك بيطق الاربعين قم تزوج الاولى لو فيك خير لما تدخل في ما لا يعنيك… 😕😅
العربية

طيب كم أعماركم يوم دريتو حول المدينة قرية جبلية اسمها الفقرة وهي باردة فعليًا طوال السنة
بتالي اهل المدينة يصيفون فيها
عزيزة الفؤاد@turtlescanfly0
او واحات المدينة وما حولها بس ذي برضو يجيها الحر عكس الطايف لذلك لا يوجد اجمل من الطايف
العربية

هذا صحته ورجولته افضل بمليون مرة من اللي يفطر معصوب ولا ساندوتش جبن سايل وميرندا
فكونا بس
نـ!!!!!يف@gg_nn660
انت تعرف ذنب التشبه بالنساء يوم تفطر زبادي يوناني وفوقه قرانولا وفراولة
العربية

@hrbqtntkhs يب لأن عضلاته فيها مستقبلات لهرموناته الذكورية إذا خفضت خفضت هرموناته، غير اصل الاستروجين وهرمونهم واحد إذا زادت الدهون جسمه بشكل تلقائي ما بيصنع التيستوستيرون لا بيروح يصنع إستروجين
العربية

@turtlescanfly0 يب
وكلما قلت الكتلة العضلية عند الرجل خصوصًا صحته راحت وطي
العربية

@hrbqtntkhs بشكل عام كثرة اكل الدهون للرجال والنساء شيء يقلل الخصوبة
العربية

@turtlescanfly0 فاهمتك
بس انا اقصد بالرجولة الخصوبة والصحة الجنسية مب المروءات والأخلاق🥰
العربية
عزيزة الفؤاد retweetledi

@ruicolu ممكن الطوب ما كان يكفي؟
بس البيوت الحجازية القديمة حسب ما اعرف أبوابها كبيرة وضخمة بس بعدين تهدمت علشان تلاءم العمارة الحديثة وقتها
العربية

يمكن أنا فان للقردة الي كانوا بيسرقوني وانا رضيعة بس ما قدروا بالنهاية 😊
GIF
عزيزة الفؤاد@turtlescanfly0
او واحات المدينة وما حولها بس ذي برضو يجيها الحر عكس الطايف لذلك لا يوجد اجمل من الطايف
العربية